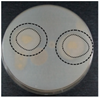
Processes 11 01161 i007 Processes 11 01161 i007
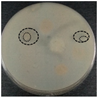
Processes 11 01161 i009 Processes 11 01161 i009

Effect of Soaking and Proteolytic Microorganisms Growth on the Protein and Amino Acid Content of Jack Bean Tempeh (Canavalia ensiformis)
Abstract
1. Introduction
2. Materials and Methods
2.1. Materials
2.2. Crude Protein
2.3. Determination of Amino Acids
2.4. Isolation of Proteolytic Microorganisms
2.4.1. Sample Preparation
2.4.2. Total Bacterial Counts for Microbiological Assessments
2.4.3. Bacteria Subculture and Purification
2.4.4. Screening Proteolytic Microorganisms by Qualitative Assay
2.5. Phenotypic Identification of Proteolytic Bacteria Using the Vitek 2.0 Compact System
2.6. Statistical Analysis
3. Results and Discussion
3.1. Crude Protein
3.2. Amino Acid Content in Raw Jack Beans and Jack Beans Soaked for 12 h
3.3. Microbial Communities from Soaked Jack Beans
3.4. Isolation and Screening of Proteolytic Microorganisms by Qualitative Assay
3.4.1. Screening of Proteolytic Microorganisms Using Skim Milk Agar (SMA)
3.4.2. Morphological Characteristics of Bacterial Isolates
3.5. Identification of Proteolytic Microorganisms by Biochemical Tests
3.5.1. Gram-Negative (GN) Bacterial Isolates
3.5.2. Gram-Positive (GP) Bacterial Isolates
4. Conclusions
Author Contributions
Funding
Data Availability Statement
Acknowledgments
Conflicts of Interest
References
- Nout, M.J.R.; Kiers, J.L. Tempe fermentation, innovation and functionality: Update into the third millenium. J. Appl. Microbiol. 2005, 98, 789–805. [Google Scholar] [CrossRef] [PubMed]
- Astuti, M.; Meliala, A.; Dalais, F.S.; Wahlqvist, M.L. Tempe, a nutritious and healthy food from Indonesia. Asia Pac. J. Clin. Nutr. 2000, 9, 322–325. [Google Scholar] [CrossRef] [PubMed]
- Zhan, S.; Ho, S.C. Meta-analysis of the effects of soy protein containing isoflavones on the lipid profile. Am. J. Clin. Nutr. 2005, 81, 397–408. [Google Scholar] [CrossRef]
- Handoyo, T.; Morita, N. Structural and functional properties of fermented soybean (Tempeh) by using Rhizopus oligosporus. Int. J. Food Prop. 2006, 9, 347–355. [Google Scholar] [CrossRef]
- Sanjukta, S.; Rai, A.K. Production of bioactive peptides during soybean fermentation and their potential health benefits. Trends Food Sci. Technol. 2016, 50, 1–10. [Google Scholar] [CrossRef]
- Pangastuti, A.; Alfisah, R.K.; Istiana, N.I.; Sari, S.L.A.; Setyaningsih, R.; Susilowati, A.; Purwoko, T. Metagenomic analysis of microbial community in over-fermented tempeh. Biodiversitas 2019, 20, 1106–1114. [Google Scholar] [CrossRef]
- Starzyńska-Janiszewska, A.; Stodolak, B.; Wikiera, A. Proteolysis in tempeh-type products obtained with Rhizopus and Aspergillus strains from grass pea (Lathyrus sativus) seeds. Acta Sci. Pol. Technol. Aliment. 2015, 14, 125–132. [Google Scholar] [CrossRef]
- Niveditha, V.R.; Sridhar, K.R. Comparison of Functional Properties of Cooked and Fermented (Rhizopus oligosporus) Beans of Canavalia Cathartica of the Coastal Sand Dunes; Elsevier Inc.: Amsterdam, The Netherlands, 2017; ISBN 9780128114124. [Google Scholar]
- Oboh, G.; Akindahunsi, A.A. Biochemical changes in cassava products (flour & gari) subjected to Saccharomyces cerevisae solid media fermentation. Food Chem. 2003, 82, 599–602. [Google Scholar] [CrossRef]
- Affandi, D.R.; Lshartani, D.; Wijaya, K. Physical, chemical and sensory characteristics of jack bean (Canavalia ensiformis) tempeh flour at various drying temperature. AIP Conf. Proc. 2020, 2219, 070004. [Google Scholar] [CrossRef]
- Michael, K.; Sogbesan, O.; Onyia, L. Effect of processing methods on the nutritional value of Canavalia ensiformis jack bean seed meal. J. Food Process. Technol. 2018, 9, 766. [Google Scholar] [CrossRef]
- Sánchez, A.; Vázquez, A. Bioactive peptides: A review. Food Qual. Saf. 2017, 1, 29–46. [Google Scholar] [CrossRef]
- Drulyte, D.; Orlien, V. The effect of processing on digestion of legume proteins. Foods 2019, 8, 224. [Google Scholar] [CrossRef] [PubMed]
- Kajihausa, O.E.; Fasasi, R.A.; Atolagbe, Y.M. Effect of different soaking time and boiling on the proximate composition and functional properties of sprouted sesame seed flour. Niger. Food J. 2014, 32, 8–15. [Google Scholar] [CrossRef]
- Efriwati; Suwanto, A.; Rahayu, G.; Nuraida, L. Population dynamics of yeasts and lactic acid bacteria (LAB) during tempeh production. HAYATI J. Biosci. 2013, 20, 57–64. [Google Scholar] [CrossRef]
- Mulyowidarso, R.K.; Fleet, G.H.; Buckle, K.A. The microbial ecology of soybean soaking for tempe production. Int. J. Food Microbiol. 1989, 8, 35–46. [Google Scholar] [CrossRef]
- Yan, Y.; Wolkers-Rooijackers, J.; Nout, M.J.R.; Han, B. Microbial diversity and dynamics of microbial communities during back-slop soaking of soybeans as determined by PCR-DGGE and molecular cloning. World J. Microbiol. Biotechnol. 2013, 29, 1969–1974. [Google Scholar] [CrossRef]
- Pujiati; Primiani, C.N. Test of protease activity on pigeon pea beans (Cajanus cajan (L.) Millsp.) fermented by Aspergillus niger. J. Biol. Res. 2018, 23, 84–89. [Google Scholar] [CrossRef]
- Gibbs, B.F.; Zougman, A.; Masse, R.; Mulligan, C. Production and characterization of bioactive peptides from soy hydrolysate and soy-fermented food. Food Res. Int. 2004, 37, 123–131. [Google Scholar] [CrossRef]
- Hachmeister, K.A.; Fung, D.Y.C. Tempeh: A mold-modified indigenous fermented food made from soybeans and/or cereal grains. Crit. Rev. Microbiol. 1993, 19, 137–188. [Google Scholar] [CrossRef]
- Yudianti, N.F.; Yanti, R.; Cahyanto, M.N.; Rahayu, E.S.; Utami, T. Isolation and characterization of lactic acid bacteria from legume soaking water of tempeh productions. Digit. Press Life Sci. 2020, 2, 00003. [Google Scholar] [CrossRef][Green Version]
- Yarlina, V.P.; Andoyo, R.; Djali, M.; Lani, M.N. Metagenomic analysis for indigenous microbial diversity in soaking process of making tempeh jack beans (Canavalia ensiformis). Curr. Res. Nutr. Food Sci. 2022, 10, 620–632. [Google Scholar] [CrossRef]
- AOAC International. Official Methods of Analysis of AOAC Internationa; AOAC: Rockville, MD, USA, 2006; p. 3172. Available online: https://www.techstreet.com/standards/official-methods-of-analysis-of-aoac-international-20th-edition-2016?product_id=1937367 (accessed on 17 December 2019).
- Radita, R.; Suwanto, A.; Kurosawa, N.; Wahyudi, A.T.; Rusmana, I. Metagenome analysis of tempeh production: Where did the bacterial community in tempeh come from? Malays. J. Microbiol. 2017, 13, 280–288. [Google Scholar] [CrossRef]
- Sanders, E.R. Aseptic laboratory techniques: Plating methods. J. Vis. Exp. 2012, 63, e3064. [Google Scholar] [CrossRef]
- Gordon, R.E.; Haynes, W.C. The Genus Bacillus. Handbook No. 427; United States Department of Agriculture: Washington, DC, USA, 1973.
- Monika; Savitri; Kumar, V.; Kumari, A.; Angmo, K.; Bhalla, T.C. Isolation and characterization of lactic acid bacteria from traditional pickles of Himachal Pradesh, India. J. Food Sci. Technol. 2017, 54, 1945–1952. [Google Scholar] [CrossRef]
- Huma, N.; Anjum, F.M.; Sehar, S.; Issa Khan, M.; Hussain, S. Effect of soaking and cooking on nutritional quality and safety of legumes. Nutr. Food Sci. 2008, 38, 570–577. [Google Scholar] [CrossRef]
- Widaningrum, N.; Sukasih, E.; Purwani, E.Y. Introductory study on processing of fermented jack bean (Canavalia ensiformis). J. Penelit. Pascapanen Pertan. 2017, 12, 129. [Google Scholar] [CrossRef]
- Hudiyanti, D.; Arya, A.P.; Siahaan, P.; Suyati, L. Chemical composition and phospholipids content of Indonesian Jack Bean (Canavalia ensiformis L.). Orient. J. Chem. 2015, 31, 2043–2046. [Google Scholar] [CrossRef]
- Kanetro, B.; Riyanto, M.; Pujimulyani, D.; Huda, N. Improvement of functional properties of Jack Bean (Canavalia ensiformis) flour by germination and its relation to amino acids profile. Curr. Res. Nutr. Food Sci. 2021, 9, 812–822. [Google Scholar] [CrossRef]
- Maquiné, T.M.; Cysne, A.Q.; de Lima, W.A.A.; Abreu, S.C.; Green, M.; Almeida Rios, S. de Germination of seeds of interspecific hybrid caiau x oil palm submitted to the mechanical depulping. Am. J. Plant Sci. 2014, 5, 2965–2972. [Google Scholar] [CrossRef]
- Handa, V.; Kumar, V.; Panghal, A.; Suri, S.; Kaur, J. Effect of soaking and germination on physicochemical and functional attributes of horsegram flour. J. Food Sci. Technol. 2017, 54, 4229–4239. [Google Scholar] [CrossRef]
- Kanetro, B. Amino acid profile of soybean (Glicine max) sprout protein for determining insulin stimulation amino acids. Int. Food Res. J. 2018, 25, 2497–2502. [Google Scholar]
- Semba, R.D.; Shardell, M.; Sakr Ashour, F.A.; Moaddel, R.; Trehan, I.; Maleta, K.M.; Ordiz, M.I.; Kraemer, K.; Khadeer, M.A.; Ferrucci, L.; et al. Child stunting is associated with low circulating essential amino acids. EBioMedicine 2016, 6, 246–252. [Google Scholar] [CrossRef] [PubMed]
- Shivakumar, N.; Kashyap, S.; Kishore, S.; Thomas, T.; Varkey, A.; Devi, S.; Preston, T.; Jahoor, F.; Sheshshayee, M.S.; Kurpad, A.V. Protein-quality evaluation of complementary foods in Indian children. Am. J. Clin. Nutr. 2019, 109, 1319–1327. [Google Scholar] [CrossRef] [PubMed]
- EL-Suhaibani, M.; Ahmed, M.A.; Osman, M.A. Study of germination, soaking and cooking effects on the nutritional quality of goat pea (Securigera securidaca L.). J. King Saud Univ.-Sci. 2020, 32, 2029–2033. [Google Scholar] [CrossRef]
- Fernandes, A.C.; Nishida, W.; Da Costa Proença, R.P. Influence of soaking on the nutritional quality of common beans (Phaseolus vulgaris L.) cooked with or without the soaking water: A review. Int. J. Food Sci. Technol. 2010, 45, 2209–2218. [Google Scholar] [CrossRef]
- Wongsiri, S.; Ohshima, T.; Duangmal, K. Chemical composition, amino acid profile and antioxidant activities of germinated Mung beans (Vigna radiata). J. Food Process. Preserv. 2015, 39, 1956–1964. [Google Scholar] [CrossRef]
- Seena, S.; Sridhar, K.R.; Jung, K. Nutritional and antinutritional evaluation of raw and processed seeds of a wild legume, Canavalia cathartica of coastal sand dunes of India. Food Chem. 2005, 92, 465–472. [Google Scholar] [CrossRef]
- Sujak, A.; Kotlarz, A.; Strobel, W.; Boniecka, J. Chemical composition and nutritional quality of seeds of different jack bean (Canavalia ensiformis L.) landraces. Food Chem. 2014, 145, 886–892. [Google Scholar] [CrossRef]
- Ogunsina, B.S.; Radha, C.; Indrani, D.; Mukherjee, R. Influence of soaking and dehulling on cooking quality, protein profile and in vitro protein digestibility of two indigenous varieties of Nigerian brown beans (Phaseolus vulgaris L.). J. Agric. Food Chem. 2007, 55, 10282–10290. [Google Scholar] [CrossRef]
- Newsholme, P.; Bender, K.; Kiely, A.; Brennan, L. Amino acid metabolism, insulin secretion and diabetes. Biochem. Soc. Trans. 2007, 35, 1180–1186. [Google Scholar] [CrossRef]
- El-safy, S.; Salem, H.A.; Mukhtar, E. The impact of soaking and germination on chemical composition, carbohydrate fractions, digestibility, antinutritional factors and minerals content of some legumes and cereals grain seeds. Alex. Sci. Exch. J. Int. Q. J. Sci. Agric. Environ. 2013, 34, 499–513. [Google Scholar] [CrossRef]
- Verdier, T.; Coutand, M.; Bertron, A.; Roques, C. A review of indoor microbial growth across building materials and sampling and analysis methods. Bulding Environ. 2014, 80, 136–149. [Google Scholar] [CrossRef]
- Sharma, M.; Gat, Y.; Arya, S.; Kumar, V.; Panghal, A.; Kumar, A. A review on microbial alkaline protease: An essential tool for various industrial approaches. Ind. Biotechnol. 2019, 15, 69–78. [Google Scholar] [CrossRef]
- Salleh, F.; Lani, M.N.; Chilek, T.Z.T.; Kamaruding, N.A.; Ismail, N. Lactic acid bacteria producing sorbic acid and benzoic acid compounds from fermented durian flesh (Tempoyak) and their antibacterial activities against foodborne pathogenic bacteria. Appl. Food Biotechnol. 2021, 8, 121–132. [Google Scholar] [CrossRef]
- Lani, M.N.; Zainudin, A.H.; Razak, S.B.A.; Mansor, A.; Hassan, Z. Microbiological quality and pH changes of honey produced by stingless bees, Heterotrigona itama and Geniotrigona thoracica stored at ambient temperature. Malays. Appl. Biol. 2017, 46, 89–96. [Google Scholar]
- Halim, N.R.A.; Shukri, W.H.Z.; Lani, M.N.; Sarbon, N.M. Effect of different hydrocolloids on the physicochemical properties, microbiological quality and sensory acceptance of fermented cassava (tapai ubi) ice cream. Int. Food Res. J. 2014, 21, 1825–1836. [Google Scholar]
- Utama, C.S.; Zuprizal; Hanim, C. Wihandoyo Isolation and identification of cellulolytic lactic acid bacteria derived from fermented cabbage juice. J. Apl. Teknol. Pangan 2018, 7, 1–6. [Google Scholar]
- Hamdani, S.; Asstiyani, N.; Astriany, D.; Singgih, M.; Ibrahim, S. Isolation and identification of proteolytic bacteria from pig sludge and protease activity determination. IOP Conf. Ser. Earth Environ. Sci. 2019, 230, 012095. [Google Scholar] [CrossRef]
- Yulifianti, R.; Ginting, E. Proteolytic activity of selected moulds in the first fermentation of black-seeded soysauce. IOP Conf. Ser. Earth Environ. Sci. 2018, 102, 012097. [Google Scholar] [CrossRef]
- Yusmarini, Y.; Indrati, R.; Utami, T.; Marsono, Y. Isolasi dan identifikasi bakteri asam laktat proteolitik dari susu kedelai yang terfermentasi spontan. J. Natur Indones. 2012, 12, 28. [Google Scholar] [CrossRef]
- Alnahdi, H.S. Isolation and screening of extracellular proteases produced by new isolated Bacillus sp. J. Appl. Pharm. Sci. 2012, 2, 071–074. [Google Scholar] [CrossRef]
- Nuraini, C.; Saida; Suryanti; Nontji, M. Isolation and identification bakteria from corn rhizofer on vegetative and generative phase. J. Agrotekmas 2011, 1, 24–30. [Google Scholar]
- Ravea, A.F.G.; Kussb, A.V.; Peila, G.H.S.; Ladeirac, S.R.; Villarreald, J.P.V.; Nascentee, P.S. Biochemical identification techniques and antibiotic susceptibility profile of lipolytic ambiental bacteria from effluents. Braz. J. Biol. 2019, 79, 555–565. [Google Scholar] [CrossRef] [PubMed]
- Funke, G.; Monnet, D.; DeBernardis, C.; Von Graevenitz, A.; Freney, J. Evaluation of the VITEK 2 system for rapid identification of medically relevant gram-negative rods. J. Clin. Microbiol. 1998, 36, 1948–1952. [Google Scholar] [CrossRef]
- Elems, C.; Finnigan, J.; Fraser, G.; Garza, A.; Glover, J.; Hanson, P.; Hayman, M.; High, E.; Johnson, L.; Kelly, M.; et al. Identification test card: Collaborative study. J. AOAC Int. Int. Vol. 2012, 95, 1425–1432. [Google Scholar] [CrossRef]
- Biomerieux SA. Vitek 2 Product Information; Biomerieux SA: Marcy-l’Étoile, France, 2016. [Google Scholar]
- Hiremath, P.S.; Bannigidad, P. Automated Gram-staining characterisation of bacterial cells using colour and cell wall properties. Int. J. Biomed. Eng. Technol. 2011, 7, 257–265. [Google Scholar] [CrossRef]
- Alaidarous, M.; Alanazi, M.; Abdel-Hadi, A. Isolation, identification, and antimicrobial susceptibility of bacteria associated with waterpipe contaminants in selected area of Saudi Arabia. BioMed Res. Int. 2017, 2017, 8042603. [Google Scholar] [CrossRef]
- Molloy, K.; Smith, S.G.; Cagney, G.; Dillon, E.T.; Greene, C.M.; McElvaney, N.G. Characterisation of the major extracellular proteases of Stenotrophomoas maltophilia and their effects on pulmonary antiproteases. Pathogens 2019, 8, 92. [Google Scholar] [CrossRef]
- Sumathy, J. A study on the Enterobacteriaceae pathogen Klebsiella pneumoniae isolated from sewage and drinking water environment. IOSR J. Biotechnol. Biochem. 2018, 4, 1–5. [Google Scholar] [CrossRef]
- Yerlikaya, O.; Akbulut, N. In vitro characterisation of probiotic properties of Enterococcus faecium and Enterococcus durans strains isolated from raw milk and traditional dairy products. Int. J. Dairy Technol. 2020, 73, 98–107. [Google Scholar] [CrossRef]
- Ben Braïek, O.; Smaoui, S. Enterococci: Between emerging pathogens and potential probiotics. BioMed Res. Int. 2019, 2019, 5938210. [Google Scholar] [CrossRef] [PubMed]
- Moa, H.; Kariluoto, S.; Piironen, V.; Zhu, Y.; Sanders, M.G.; Vincken, J.P.; Wolkers-Rooijackers, J.; Nout, M.J.R. Effect of soybean processing on content and bioaccessibility of folate, vitamin B12 and isoflavones in tofu and tempe. Food Chem. 2013, 141, 2418–2425. [Google Scholar] [CrossRef] [PubMed]
- Toe, C.J.; Foo, H.L.; Loh, T.C.; Mohamad, R.; Rahim, R.A.; Idrus, Z. Extracellular proteolytic activity and amino acid production by lactic acid bacteria isolated from Malaysian foods. Int. J. Mol. Sci. 2019, 20, 1777. [Google Scholar] [CrossRef] [PubMed]
- Lim, Y.H.; Foo, H.L.; Loh, T.C.; Mohamad, R.; Abdullah, N. Comparative studies of versatile extracellular proteolytic activities of lactic acid bacteria and their potential for extracellular amino acid productions as feed supplements. J. Anim. Sci. Biotechnol. 2019, 10, 15. [Google Scholar] [CrossRef]


| Soaking Time (h) | Plate Count Agar (log10 CFU g−1) | Yeast and Mold Agar (log10 CFU g−1) | de Man Rogosa and Sharpe Agar (log10 CFU g−1) | pH |
|---|---|---|---|---|
| 0 h | 5.50 ± 0.07 a | 5.68 ± 0.06 a | 3.22 ± 0.06 a | 7.00 ± 0.00 c |
| 12 h | 6.58 ± 0.06 b | 6.68 ± 0.00 b | 4.18 ± 0.14 b | 6.42 ± 0.23 b |
| 24 h | 7.66 ± 0.01 c | 7.62 ± 0.03 c | 5.04 ± 0.00 c | 5.96 ± 0.25 a |
| 36 h | 7.37 ± 0.13 d | 7.97 ± 0.09 d | 6.35 ± 0.50 d | 5.93 ± 0.30 a |
| 48 h | 9.70 ± 0.06 e | 9.65 ± 0.08 e | 7.66 ± 0.43 e | 5.89 ± 0.27 a |
| No | Isolate | ||||||
|---|---|---|---|---|---|---|---|
| 1 | 2 | 3 | 4 | 5 | 6 | 7 | |
| Soaking Time | 0 h | 12 h | 12 h | 12 h | 12 h | 24 h | 48 h |
All diameter![]() (mm) | 35.6 ± 0.14 | 32.7 ± 0.57 | 22.7 ± 0.85 | 25.55 ± 3.18 | 23.0 ± 0.70 | 29.65 ± 1.20 | 10.2 ± 0.14 |
Colony’s diameter![]() (mm) | 13.2 ± 2.97 | 10.75 ± 0.35 | 11.4 ± 0.14 | 14.9 ± 2.55 | 1.92 ± 0.14 | 20.1 ± 0.14 | 5.05 ± 1.91 |
| Clear zone diameter (mm) | 22.4 ± 2.82 | 21.95 ± 0.99 | 11.30 ± 0.99 | 10.65 ± 0.63 | 3.8 ± 0.57 | 9.55 ± 1.06 | 5.15 ± 1.77 |
![]() | ![]() | ![]() | ![]() | ![]() | ![]() | ![]() | |
| No. | Isolate | Soaking Time | Texture | Color | Shape | Elevation | Gram Staining | |
|---|---|---|---|---|---|---|---|---|
| Rod | Coccus | |||||||
| 1 | Isolate 1 | 0 h | Smooth | Cream | √ | X | Convex | negative |
| 2 | Isolate 2 | 12 h | Smooth | Cream | √ | X | Convex | negative |
| 3 | Isolate 3 | 12 h | Smooth | Cream | √ | X | Convex | negative |
| 4 | Isolate 4 | 12 h | Smooth | Cream | x | √ | Flat | positive |
| 5 | Isolate 5 | 12 h | Smooth | White | x | √ | Flat | positive |
| 6 | Isolate 6 | 24 h | Smooth | Cream | x | √ | Flat | positive |
| 7 | Isolate 7 | 48 h | Smooth | White | x | √ | Flat | positive |
| Isolate | Isolate 1 | Isolate 2 | Isolate 3 |
|---|---|---|---|
| Soaking Time | 0 h | 12 h | 12 h |
| Result | Stenorophomonas maltophilia | Cronobacter sakazakii | Klebsiella pneumonia spp. |
| Degree of accuracy in identification | 99% excellent | 99% excellent | 97% excellent |
| Isolate | Isolate 4 | Isolate 5 | Isolate 6 | Isolate 7 |
|---|---|---|---|---|
| Soaking Time | 12 h | 12 h | 24 h | 48 h |
| Result | Enterococcus durans | Staphylococcus aureus | Enterococcus faecium | Pediococcus pentosaceus |
| Degree of accuracy in identification | 99% excellent | 99% excellent | 95% very good | 88% acceptable |
Disclaimer/Publisher’s Note: The statements, opinions and data contained in all publications are solely those of the individual author(s) and contributor(s) and not of MDPI and/or the editor(s). MDPI and/or the editor(s) disclaim responsibility for any injury to people or property resulting from any ideas, methods, instructions or products referred to in the content. |
© 2023 by the authors. Licensee MDPI, Basel, Switzerland. This article is an open access article distributed under the terms and conditions of the Creative Commons Attribution (CC BY) license (https://creativecommons.org/licenses/by/4.0/).
Share and Cite
Yarlina, V.P.; Djali, M.; Andoyo, R.; Lani, M.N.; Rifqi, M. Effect of Soaking and Proteolytic Microorganisms Growth on the Protein and Amino Acid Content of Jack Bean Tempeh (Canavalia ensiformis). Processes 2023, 11, 1161. https://doi.org/10.3390/pr11041161
Yarlina VP, Djali M, Andoyo R, Lani MN, Rifqi M. Effect of Soaking and Proteolytic Microorganisms Growth on the Protein and Amino Acid Content of Jack Bean Tempeh (Canavalia ensiformis). Processes. 2023; 11(4):1161. https://doi.org/10.3390/pr11041161
Chicago/Turabian StyleYarlina, Vira Putri, Mohammad Djali, Robi Andoyo, Mohd Nizam Lani, and Muhammad Rifqi. 2023. "Effect of Soaking and Proteolytic Microorganisms Growth on the Protein and Amino Acid Content of Jack Bean Tempeh (Canavalia ensiformis)" Processes 11, no. 4: 1161. https://doi.org/10.3390/pr11041161
APA StyleYarlina, V. P., Djali, M., Andoyo, R., Lani, M. N., & Rifqi, M. (2023). Effect of Soaking and Proteolytic Microorganisms Growth on the Protein and Amino Acid Content of Jack Bean Tempeh (Canavalia ensiformis). Processes, 11(4), 1161. https://doi.org/10.3390/pr11041161